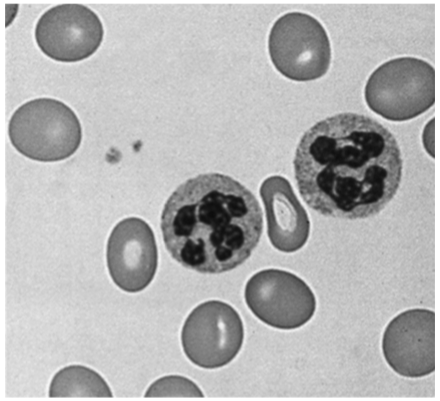
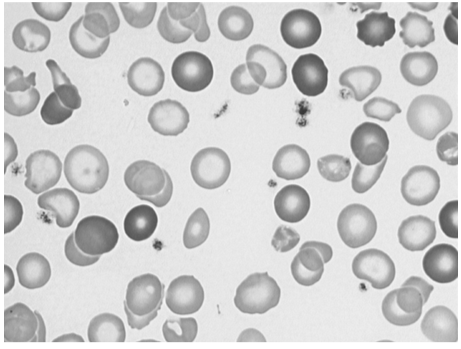
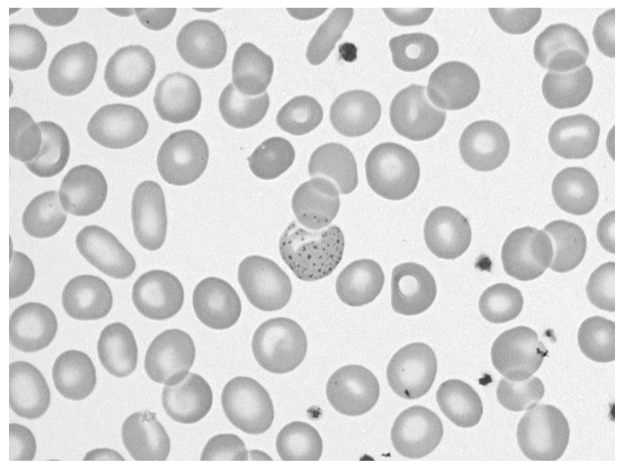
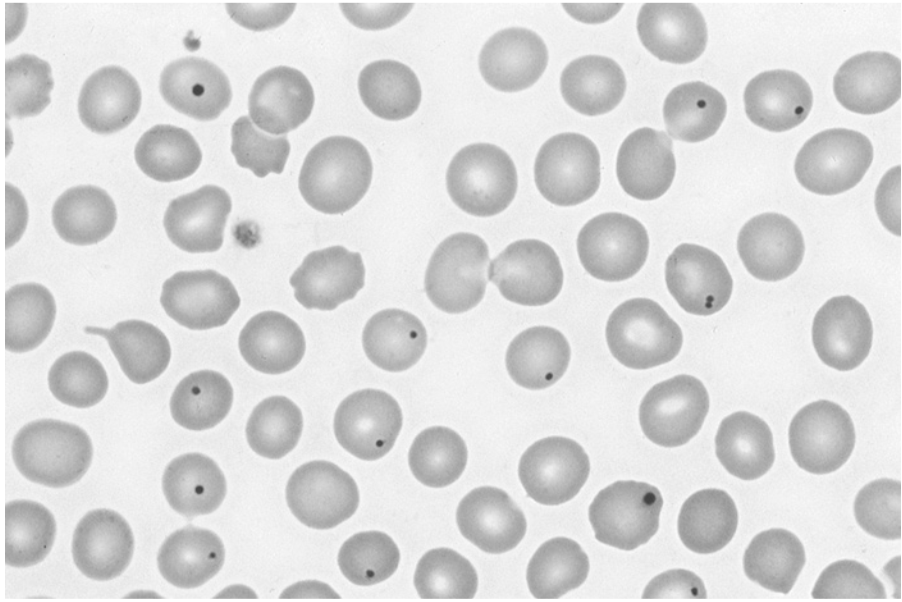
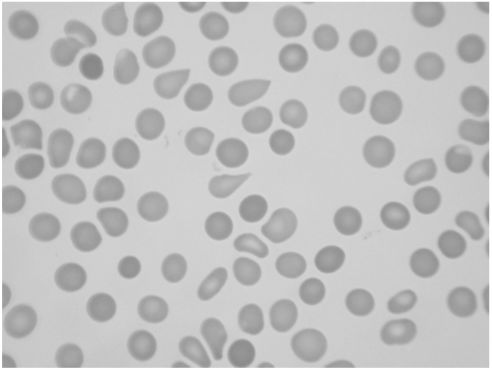
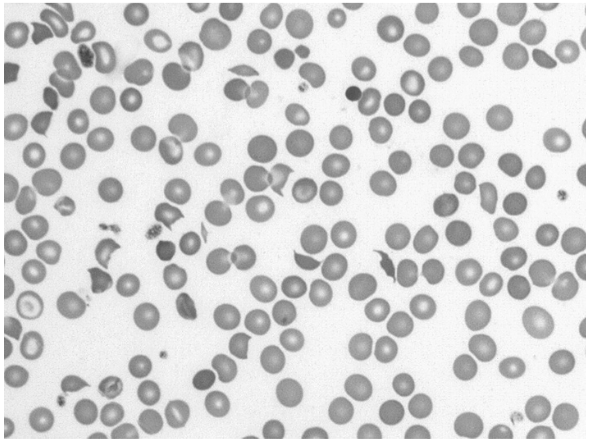
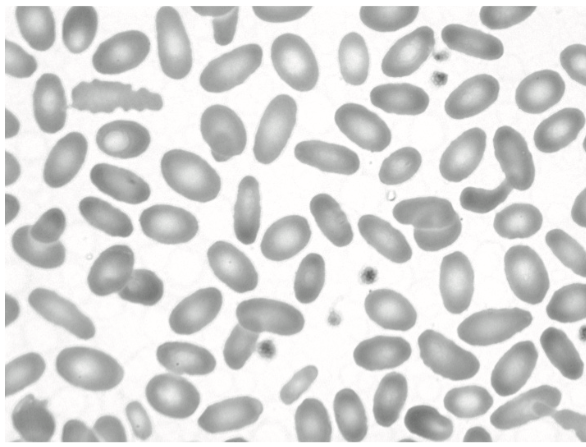
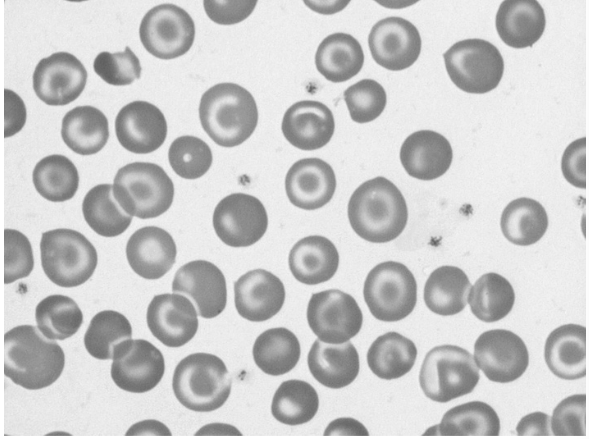
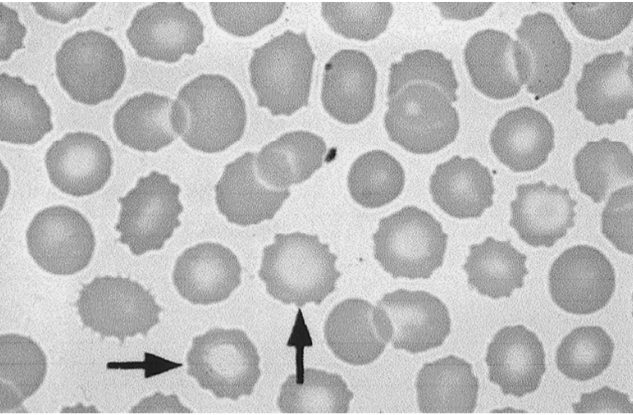
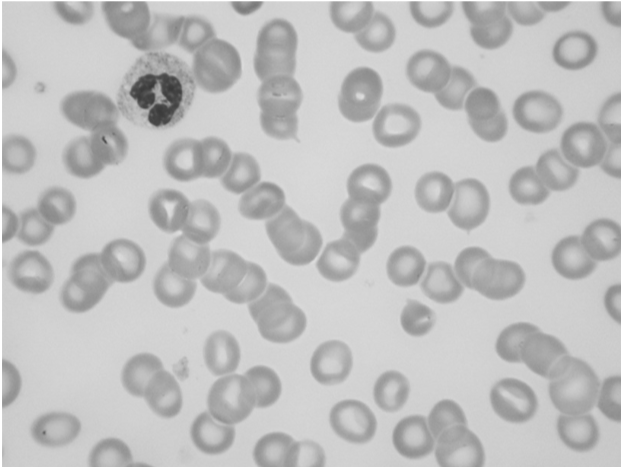

Define anemia
Hemoglobin
< 12 mg/dL in women
< 14 mg/dL in men
What are the symptoms and signs of anemia?
Symptoms: Fatigue, dyspnea on exertion, light-headedness, dizziness, syncope, palpitations, angina, and claudication.
Signs: Tachycardia, pallor (especially of the sclera and mucous membranes), systolic ejection murmurs (from high flow), and signs of the underlying cause (e.g., jaundice, pigment gallstones in hemolytic anemia, positive stool guaiac with a GI bleed).
What are the 5 important elements of the history when anemia is present?
Important points include:
What medications can cause anemia? How?
Methyldopa, penicillins, sulfa drugs - cause RBC antibodies with subsequent hemolysis
chloroquine, sulfa drugs - cause hemolysis in patients with G6PD
phenytoin - causes megaloblastic anemia through interference with folate metabolism
chloramphenicol, cancer drugs, zidovudine - cause aplastic anemia and bone marrow suppression.
What test should be ordered first to help determine the cause of anemia?
CBC
After CBC indicates anemia, what is theoretically the next test that should be ordered?
peripheral blood smear, as there are many classic findings that can help make the diagnosis
What is this peripheral blood cell classic for?

Sickled cells (sickle cell disease)
What is this peripheral blood cell classic for?
Hypersegmented neutrophils (folate/B12 deficiency)
What is this peripheral blood cell classic for?
Hypochromic and microcytic RBCs (iron deficiency)
What is this peripheral blood cell classic for?
Basophilic stippling (lead poisoning)
What is this peripheral blood cell classic for?

Heinz bodies (glucose-6-phosphatase deficiency)
What is this peripheral blood cell classic for?

“Bite cells” (classically, glucose-6-phosphatase deficiency; other hemolytic anemias
What is this peripheral blood cell classic for?
Howell-Jolly bodies (asplenia)
What is this peripheral blood cell classic for?
Teardrop-shaped RBCs (myelofibrosis)
What is this peripheral blood cell classic for?
Schistocytes, helmet cells, and fragmented RBCs (intravascular hemolysis)
What is this peripheral blood cell classic for?

Spherocytes and elliptocytes (hereditary spherocytosis and elliptocytosis)
What is this peripheral blood cell classic for?

Acanthocytes and spur cells (abetalipoproteinemia)
What is this peripheral blood cell classic for?
Target cells (thalassemia, liver disease)
What is this peripheral blood cell classic for?
Echinocytes, including “burr” cells and acanthocytes (uremia)
What is this peripheral blood cell classic for?

Polychromasia (from reticulocytosis; should alert you to the possibility of hemolysis)
What is this peripheral blood cell classic for?
Rouleaux formation (multiple myeloma)
What is this peripheral blood cell classic for?

Parasites inside red blood cells (RBCs) (malaria)
What is this peripheral blood cell classic for?

Ringed sideroblasts seen in sideroblastic anemia.
What are reticulocytes?
What should high/low values in the setting of anemia indicate?
immature RBCs.
If abnormally decreased = marrow is not responding properly and is the problem
If high = the marrow is responding properly to something causing the anemia (hemolysis, blood loss)